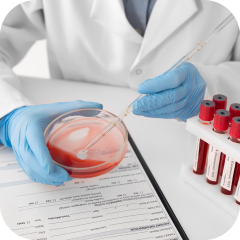
Гемостазиология

Домашняя страница
Специальности
Эксперты всех медицинских специализаций в одном месте
Абдоминальная радиология -это раздел радиологии, который использует различные методы визуализации органов брюшной полости и таза с диагностической и лечебной целью.

Абдоминальная хирургия включает в себя диагностику и оперативные вмешательства в брюшной полости

Акушерство занимается наблюдением за беременностью и лечением матери и ребенка до, во время и после родов

Аллергология - это отрасль медицины, которая занимается изучением аллергии, ее развитием, проявлением, течением и лечением

Ангиология - это раздел внутренней медицины, изучающий функции и заболевания артерий, вен и лимфатических сосудов

Андрология - медицинская специальность, изучающая пороки развития, заболевания и травмы мужских половых органов.

Бариатрическая хирургия предусматривает хирургические вмешательства, направленные на снижение показателей лишнего веса

Венерология - отрасль медицины, занимающаяся диагностикой и лечением венерических заболеваний.

Эта область медицины специализируется на хирургическом лечении заболеваний, расположенных в брюшной полости

Гастроэнтерология занимается диагностикой и лечением заболеваний желудочно-кишечного тракта.
Гемостазиология оказывает помощь при заболеваниях и проблемах, связанных со свертываемостью крови

Генетика человека - это изучение наследственности и закономерностей генов, помогающая диагностировать врожденные генетические заболевания.